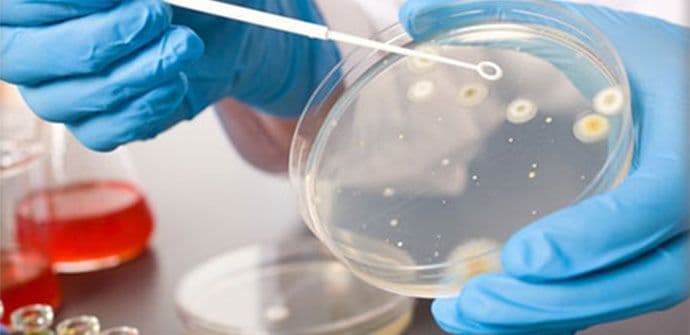
ALARM: Loša higijena, bakterije i neispravni uzorci hrane u ugostiteljskim objektima ALARM: Loša higijena, bakterije i neispravni uzorci hrane u ugostiteljskim objektima

“Pored upravnih i drugih mjera preduzetih u cilju suzbijanja sive ekonomije na tržištu robe i usluga (zabrana rada, pečaćenje, uklanjanje objekata, oduzimanje robe bez porijekla), treba istaći i mjere koje se odnose na otklanjanje nepravilnosti u pogledu sanitarnohigijenskih uslova u ugostiteljskim i prodajnim objektima. Tako su u saradnji sa Institutom za javno zdravlje, uzimani brisevi sa radnih površina, predmeta koji dolaze u dodir sa hranom i ruku zaposlenih, kao i uzoraka hrane i vode. Neispravnih uzoraka namirnica bilo je 37,98%, a neispravnih briseva 45,16%, i to u najvećem broju slučajeva zbog povećanog prisustva bakterija -loše higijene”, navodi se u Izvještaju o radu Uprave za inspekcijske poslove dostavljenom Portalu Analitika.
Što se tiče analize vode, koja je redovno vršena, treba istaći da su svi uzeti uzorci bili mikrobiološki ispravni, osim u opštini Ulcinj, zbog čega je donijeto rješenje o zabrani upotrebe vode za piće, a o istom je obaviještena javnost.
“Epidemiološka situacija u toku turističke sezone bila je očekivana i zadovoljavajuća. Pojačanim nadzorom u turističkoj sezoni uticalo se na povećanje naplate budžetskih i lokalnih prihoda, te povećanje broja registrovanih privrednih subjekata. U vezi sa tim, treba istaći uticaj koji je ostvaren na tržištu robe i usluga (evidencija robe i usluga u prometu, izdavanje računa, uplata dnevnih pazara itd.). Takođe, treba istaći pozitivan uticaj pojačanog nadzora na zaštitu života i zdravlja ljudi, kao i zaštitu i zdravlje na radu, te u konačnom na kvalitet cjelokupne turističke ponude naše zemlje”, navodi se u dokumentu.
Kao posljedica pojačanog inspekcijskog nadzora u turističkoj sezoni, povećan je broj rješenja o lokaciji za privremene objekte i odobrenja za privatni smještaj, što je, prema podacima lokalnih organa uprave nadležnih za privredu i finansije, rezultiralo povećanjem naplate lokalnih prihoda (boravišna, turistička, izletnička i komunalna taksa).
“I ove godine je, kao posledica pojačanog nadzora od strane zdravstveno-sanitarnih inspektora, bio evidentan porast broja obaveznih zdravstvenih pregleda (sanitarnih knjižica) lica zaposlenih u proizvodnji i prometu hrane”, zaključuje se u Izvještaju.
P.Z.